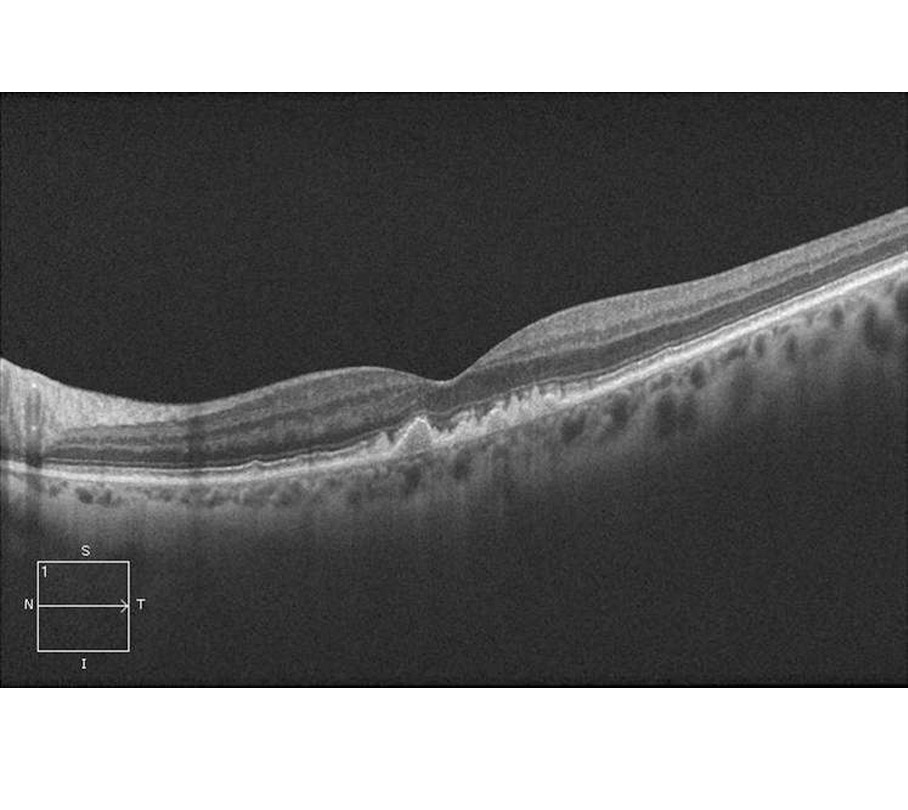
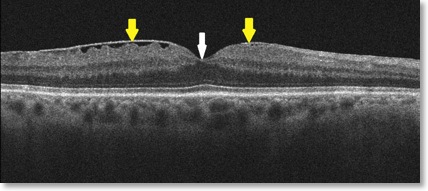

OCT - Optische Kohärenztomographie
Vorbereitung / Mitbringen
In wenigen Fällen muß die Pupille weit getropft werden, meist funktioniert aber die Untersuchung ohne Tropfen.
Kosten
Das OCT ist derzeit keine Leistung der gesetzlichen Krankenkassen. Ausnahme: einige Kassen übernehmen bei feuchter AMD bis zu 6 x im Jahr ein OCT, wenn der die Injektionen durchführende Augenarzt die Injektionen über einen besonderen Vertrag (Augenverbund, BDOC-Vertrag) abrechnet.
Auch in Fällen, bei denen ein begründeter Verdacht auf feuchte AMD oder diabetische Retinopathie besteht, kann das OCT im Rahmen der GKV-Leistungen abgerechnet werden.
Sonst kostet eine OCT-Aufnahme 85,00 €. Bei mehrfachen OCT´s in einem Jahr (Kontrolle der Makula bei Quensyl-Therapie u.ä. ) reduzieren sich die Kosten.
Tendenz Behandlungszeit
- mittel (15-20 Min.)

Beschreibung
Das OCT-Bild der Netzhaut ähnelt einem Ultraschall-Bild, nur wird es mit Licht statt mit Ultraschall aufgenommen. Es ist eine Art "Durchleuchtung der Netzhaut", eine "Schichtaufnahme der Netzhaut". Das OCT verwendet aber ungefährliches Infrarot-Licht und hat eine Auflösung der Gewebemessung von 5 µm. Damit kann man die Ablagerungen bei trockener AMD (Drusen), die Schicht der Nervenfasern und die Photorezeptoren erkennen.
Kurzer Blick auf die verschiedenen Anwendungen
OCT zur Makuladiagnostik
Die Makula bildet die Mitte der Netzhaut. Sie ist die Stelle des schärfsten Sehens und damit die wertvollste Stelle des Auges. Kommt es zu krankhaften Veränderungen in diesem Bereich, z. B. bei der altersbedingten feuchten Makula-Degeneration (feuchte AMD,s.u.), bei der diabetischen Retinopathie, bei einem Gefässverschluß an der Netzhaut oder einer entzündlichen Veränderung, so wird das zentrale Sehvermögen und damit die Lese- und Fahrfähigkeit deutlich gestört. Es entsteht ein Verzerrtsehen.
OCT-Bild: Epiretinale Gliose der Makula (Makula-pucker). Es besteht eine zusätzliche Schicht (gelbe Pfeile) auf der inneren Netzhaut. Dadurch entsteht ein Verzerrtsehen (Metamorphopsie).

OCT-Bild: feuchte Makuladegeneration. Es sind intraretinale Zysten erkennbar, Zeichen für neovaskuläre Aktivität.
OCT bei Glaukom
Mit dem Fortschreiten eines Glaukoms zeigen sich diese charakteristischen Veränderungen im OCT: die Verdünnung der retinalen Nervenfaserschicht um den Sehnerven, die Abnahme der Ganglienzellschicht und die zunehmende Aushöhlung des Sehnervenkopfes. Bis erst später, nach einem Untergang von 40-50% der Nervenfasern, schließlich auch Gesichtsfelddefekte auftreten.
"Die sichere Abgrenzung, ob das, was der Arzt sieht, ein dem Alter des Patienten entsprechender Zustand oder doch schon eine glaukomatöse Veränderung ist, stellt stets eine Herausforderung dar." - "Die hochpräzisen High-Tech-Verfahren, insbesondere die OCT, ermöglichen es, verlässlicher zu unterscheiden, ob es sich um einen natürlichen altersbedingten Schwund des neuroretinalen Randsaums und der retinalen Nervenfaserschicht oder um frühe Glaukomschäden handelt" (Prof. Dr. Mardin, Uniklinik Erlangen).

OCT-Auswertung der Nervenfaserschicht bei beginnendem Glaukom. Am rechten Auge (OD) ist ein rechter oberer Sektor gelb markiert. An beiden Augen zeigen die roten Pfeile eine Verdünnung der Nervenfaserschicht im Vergleich zu altersgleichen Patienten an.